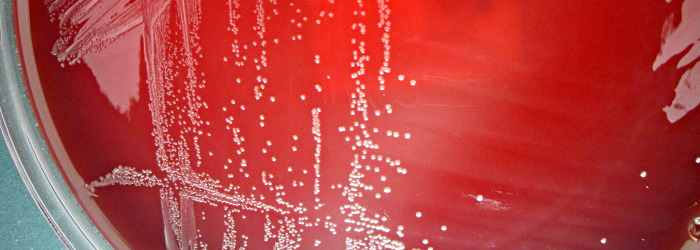

25 Jahre Forschung mit Whitley-Arbeitsstationen
Wir sind stolz darauf, zu zeigen, wie Whitley-Arbeitsstationen weiterhin eine zentrale Rolle in der bahnbrechenden mikrobiologischen Forschung im gesamten Vereinigten Königreich spielen.
Eine der Einrichtungen, mit denen wir seit über zwei Jahrzehnten eng zusammenarbeiten, ist die Londoner Hochschule für Hygiene und Tropenmedizin (London School of Hygiene & Tropical Medicine, LSHTM).
Wir haben mit Dr. Ozan Gundogdu, Associate Professor an der LSHTM, darüber gesprochen, wie Whitley-Arbeitsstationen ihre Forschungsarbeit unterstützen.
Eine langjährige Partnerschaft
Die LSHTM arbeitet bereits seit 1999 mit Don Whitley Scientific (DWS) zusammen – und blickt somit auf 25 Jahre kontinuierlicher Nutzung von Arbeitsstationen und technischem Service zurück.
Begonnen hat alles in den 1990er-Jahren mit unseren ersten variablen Atmosphärenschränken. Seitdem hat sich die LSHTM immer wieder für Whitley-Arbeitsstationen entschieden und ihre Serviceverträge konsequent fortgeführt – ein Garant für die langfristige Leistungsfähigkeit und Zuverlässigkeit der Geräte.
In diesem Sommer installierte DWS zwei neue Arbeitsstationen an der Hochschule, die die bisherigen Modelle ersetzen, welche über zwei Jahrzehnte zuverlässig im Einsatz waren.
Diese neuen Modelle verfügen über eine Reihe fortschrittlicher Funktionen, darunter Datenaufzeichnung mit Sauerstoffprofilierung, ein automatisches Gassystem für die Handschuhe, seitliche Schleusen mit mehreren Kabelanschlüssen, einen Vakuumanschluss sowie ein Befeuchtungssystem, das optimale Bedingungen für das Wachstum von Campylobacter gewährleistet.
All diese Funktionen sorgen gemeinsam für die Stabilität und Flexibilität, die für komplexe mikrobiologische Experimente erforderlich sind.
Forschungsschwerpunkt: Campylobacter
An der LSHTM werden Whitley-Arbeitsstationen vor allem für die Kultivierung von Campylobacter eingesetzt – einem mikroaerophilen Bakterium, das als eine der weltweit führenden Ursachen für Durchfallerkrankungen gilt. Campylobacter ist außerdem der häufigste bakterielle Erreger von Gastroenteritis beim Menschen weltweit.
Dr. Gundogdu erklärt:
„Ohne diese Geräte müssten wir auf Gasgläser zurückgreifen, was unsere Experimente stark einschränken würde.
Die mikroaeroben Arbeitsstationen bieten uns enorme Flexibilität und haben es uns ermöglicht, die Physiologie und Pathogenese des Bakteriums über mehr als zwei Jahrzehnte hinweg zu erforschen.
Mit diesen grundlegenden Erkenntnissen können wir Interventions- und Kontrollstrategien entwickeln.“
Merkmale, die den Unterschied machen
Auf die Frage, welche Aspekte der Arbeitsstationen er am meisten schätzt, hebt Dr. Gundogdu hervor:
die Zuverlässigkeit der für das Bakterienwachstum notwendigen Bedingungen, die einfache Temperaturregelung sowie den praktischen seitlichen Zugang zum Einbringen von Kulturschalen.
Gemeinsam schaffen diese Merkmale eine kontrollierte Umgebung, die den Forschungsfortschritt beschleunigt und die Ergebnisse verbessert.
Auf Vertrauen gebaut
Neben der Technologie schätzt das LSHTM-Team auch die Menschen hinter den Produkten:
„Der Grund, warum wir Don Whitley Scientific seit so vielen Jahren treu sind, liegt in den Beziehungen, die wir zu den Mitarbeitenden aufgebaut haben.
Sie sind äußerst hilfsbereit und kompetent. Diese Beziehungen ermöglichen es uns, technische Herausforderungen im Zusammenhang mit unseren Experimenten zu besprechen und unsere Forschung weiter voranzutreiben.“
Blick in die Zukunft
Mit ihren neuen Arbeitsstationen setzt die LSHTM ihre führende mikrobiologische Forschung mit Zuversicht und Präzision fort.
Wir sind stolz darauf, ihre Arbeit zu unterstützen – und gespannt auf die Entdeckungen, die das nächste Kapitel bringen wird.
de
xEnglish